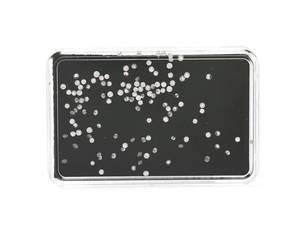
DIAMANTER

DIAMANTER
DIAMANTER, briljantslipade, 1,55 ctv, 0,01 - 0,02 ct st, ca W-TCape/SI-P.
- 2016-10-20 13:00:00
- Kaplans Auktioner
- Länk till objektet
Slutpris:2 000 SEK
Avslutade auktioner liknande DIAMANTER

W.A. Bolin
W.A. Bolin, collier av odlade pärlor samt lås i 18K vitguld med infattad smaragd och diamanter, Stockholm 1960 Doserat tre-radigt collier med lås på vänster Läs mer...
- 2024-03-30
- Bukowskis
- 64 000 SEK

ARMBAND, platina, art déco, 1900-talets första h...
7 genombrutna länkar med 7 gammalslipade diamanter (kvalitet ca I/VS-SI) samt ca 224 åttkantslipade diamanter tot ca 7,50 ct enligt tidigare uppgift, senare säkerhetskedja av Läs mer...
- 2024-05-13
- Olséns Auktioner
- 44 000 SEK

Ring 18K vitguld med runda briljantslipade diamant...
Diamanter ca 0,54 ct totalt, färg och klarhet ca H/P, infattning mäter 9,8 mm bredd, infattningens längd ut på ringskenan 19,5 mm, höjd 6 mm, Läs mer...
- 2024-09-11
- Bukowskis
- 6 000 SEK

Örhängen, W.A Bolin, ett par, 18K vitguld med p�...
Skruv stämplad WAB, Stockholm 1951. Två briljantslipade diamanter totalt ca 0.50 ct, samt små åttkantslipade och rosenslipade diamanter. Längd ca 20 mm. Vikt 5 g. Läs mer...
- 2024-09-22
- Bukowskis
- 7 400 SEK

Efva Attling
Efva Attling, örhängen ett par "Beam & Stars Two Ear" rodiumpläterat sterlingsilver med runda briljantslipade diamanter I form av stjärnor i två storlekar med infattade Läs mer...
- 2024-09-25
- Bukowskis
- 8 200 SEK

Örhängen med briljantslipade diamanter medfölja...
Diamanter 0,31 ct och 0,30 ct G/si2 enligt HRD report nr 190000108351 och 190000151240. Krans med briljantslipade diamanter. Diamanter totalt ca 1,04 ct. 18K vitguld. Läs mer...
- 2023-12-18
- Bukowskis
- 15 000 SEK

Halsband av odlade pärlor med lås 18K vitguld oc...
Diamanter ca 0,06 ct totalt, låset mäter 16,9x14,8x10,8 mm, odlade pärlornas diameter ca 7 mm, halsbandets längd ca 42 cm Två diamanter med smärre kantnagg Läs mer...
- 2024-08-28
- Bukowskis
- 3 000 SEK

Halsband 18K guld och runda briljantslipade diaman...
Diamanter ca 1,20 ct totalt, hänget i form av en blomma mäter 28x30 mm, kedjans längd 42 cm, vikt ca 13,2 gram Enstaka diamanter med Läs mer...
- 2024-09-10
- Bukowskis
- 11 500 SEK

DIAMANTER, 34
DIAMANTER, 34 briljantslipade 3,18 ctv, ca TW-W/VS-SI, diamanter med nagg på kuletten. Läs mer...
- 2024-08-29
- Kaplans Auktioner
- 11 200 SEK

TENNISARMBAND, 18K
TENNISARMBAND, 18K roséguld/vitguld, 15 briljantslipade diamanter ca 0,60 ctv, ca TW-Cr/P, 47 bruna briljantslipade diamanter ca 1,20 ctv, längd 18 cm, vikt 7,7 g, flera Läs mer...
- 2024-08-17
- Kaplans Auktioner
- 7 000 SEK